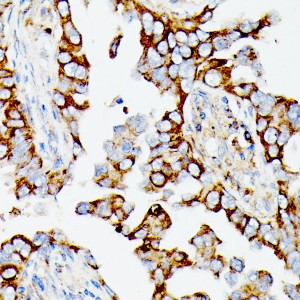
KO-Validated MAP3K1 Rabbit pAb (20 μl)

KO-Validated MAP3K1 Rabbit pAb (20 μl)
| Reactivity: | Human, Mouse, Rat |
| Applications: | WB, IHC, ELISA |
| Host Species: | Rabbit |
| Isotype: | IgG |
| Clonality: | Polyclonal antibody |
| Gene Name: | mitogen-activated protein kinase kinase kinase 1 |
| Gene Symbol: | MAP3K1 |
| Synonyms: | MEKK; MEKK1; SRXY6; MEKK 1; MAPKKK1; K1 |
| Gene ID: | 4214 |
| UniProt ID: | Q13233 |
| Immunogen: | A synthetic peptide corresponding to a sequence within amino acids 1400-1512 of human MAP3K1 (NP_005912.1). |
| Dilution: | WB 1:500-1:2000; IHC 1:50-1:200 |
| Purification Method: | Affinity purification |
| Concentration: | 2.87 mg/ml |
| Buffer: | PBS with 0.01% thimerosal, 50% glycerol, pH7.3. |
| Storage: | Store at -20°C. Avoid freeze / thaw cycles. |
| Documents: | Manual-MAP3K1 polyclonal antibody |
Background
The protein encoded by this gene is a serine/threonine kinase and is part of some signal transduction cascades, including the ERK and JNK kinase pathways as well as the NF-kappa-B pathway. The encoded protein is activated by autophosphorylation and requires magnesium as a cofactor in phosphorylating other proteins. This protein has E3 ligase activity conferred by a plant homeodomain (PHD) in its N-terminus and phospho-kinase activity conferred by a kinase domain in its C-terminus.
Images
 | Western blot analysis of lysates from wild type (WT) and MAP3K1 knockout (KO) HeLa cells, using [KO Validated] MAP3K1 Rabbit pAb (A18041) at 1:1000 dilution. Secondary antibody: HRP-conjugated Goat anti-Rabbit IgG (H+L) (AS014) at 1:10000 dilution. Lysates/proteins: 25μg per lane. Blocking buffer: 3% nonfat dry milk in TBST. Detection: ECL Basic Kit (RM00020). Exposure time: 1min. |
 | Western blot analysis of various lysates using MAP3K1 (A18041) at 1:1000 dilution. Secondary antibody: HRP-conjugated Goat anti-Rabbit IgG (H+L) (AS014) at 1:10000 dilution. Lysates/proteins: 25μg per lane. Blocking buffer: 3% nonfat dry milk in TBST. Detection: ECL Basic Kit (RM00020). Exposure time: 30s. |
 | Immunohistochemistry analysis of paraffin-embedded Human lung cancer tissue using MAP3K1 Rabbit pAb (A18041) at a dilution of 1:100 (40x lens). Microwave antigen retrieval was performed with 0.01 M Tris-EDTA repair solution (pH 9.0) prior to IHC staining. |
 | Immunohistochemistry analysis of paraffin-embedded Human liver cancer tissue using MAP3K1 Rabbit pAb (A18041) at a dilution of 1:100 (40x lens). Microwave antigen retrieval was performed with 0.01 M Tris-EDTA repair solution (pH 9.0) prior to IHC staining. |
 | Immunohistochemistry analysis of paraffin-embedded Human esophagus tissue using MAP3K1 Rabbit pAb (A18041) at a dilution of 1:100 (40x lens). Microwave antigen retrieval was performed with 0.01 M Tris-EDTA repair solution (pH 9.0) prior to IHC staining. |
 | Immunohistochemistry analysis of paraffin-embedded Mouse liver tissue using MAP3K1 Rabbit pAb (A18041) at a dilution of 1:100 (40x lens). Microwave antigen retrieval was performed with 0.01 M Tris-EDTA repair solution (pH 9.0) prior to IHC staining. |
 | Immunohistochemistry analysis of paraffin-embedded Mouse spleen tissue using MAP3K1 Rabbit pAb (A18041) at a dilution of 1:100 (40x lens). Microwave antigen retrieval was performed with 0.01 M Tris-EDTA repair solution (pH 9.0) prior to IHC staining. |
 | Immunohistochemistry analysis of paraffin-embedded Rat spleen tissue using MAP3K1 Rabbit pAb (A18041) at a dilution of 1:100 (40x lens). Microwave antigen retrieval was performed with 0.01 M Tris-EDTA repair solution (pH 9.0) prior to IHC staining. |
You may also be interested in: